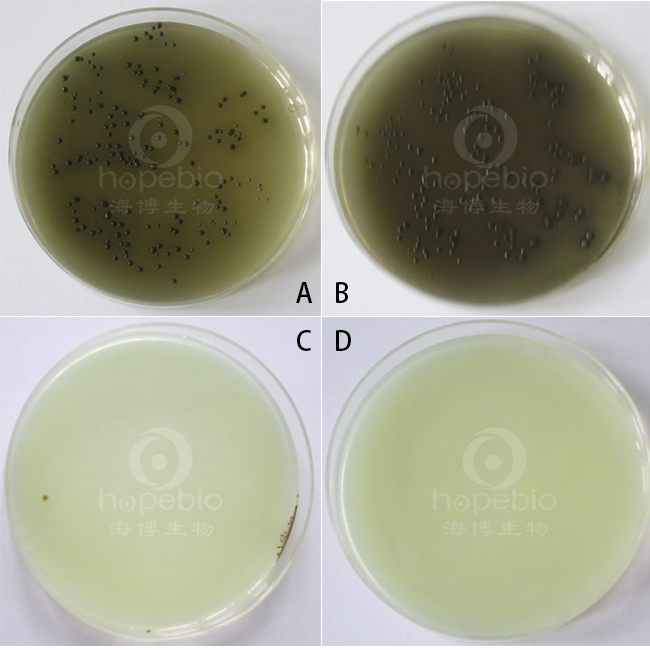

海博微信公众号
海博微信公众号
 海博天猫旗舰店
海博天猫旗舰店


 海博微信公众号
海博微信公众号
 海博天猫旗舰店
海博天猫旗舰店




一、试验原理:
本培养基用于食品微生物检验中沙门氏菌的选择性培养。
蛋白胨、牛肉粉在培养基中作为基础营养物质,为细菌的生长提供所需的碳源、氮源、维生素以及一些矿物质等元素;葡萄糖可作为细菌生长代谢所需的能量物质;磷酸氢二钠作为培养基pH缓冲剂。煌绿和亚硫酸钠能够抑制大肠杆菌、变形杆菌和革兰氏阳性菌的生长,但对伤寒、副伤寒等沙门氏菌的生长没有影响。伤寒沙门氏菌和其他沙门氏菌能利用葡萄糖,将亚硫酸盐还原成硫化物并与硫酸亚铁反应使得菌落呈黑色,此外还可以吧铋离子还原成金属铋,使菌落呈现金属光泽,从而使沙门氏菌得到分离。
二、培养基配方(g/L):
|
蛋白胨 |
10.0 |
|
牛肉浸粉 |
5.0 |
|
硫酸亚铁 |
0.3 |
|
柠檬酸铋铵 |
2.0 |
|
亚硫酸钠 |
6.0 |
|
磷酸氢二钠 |
4.0 |
|
葡萄糖 |
5.0 |
|
煌绿 |
0.025 |
|
琼脂 |
20.0 |
|
pH 7.5±0.2 25℃ |
|
三、试验方法:
称取本品干粉50.3g,加入1000m L蒸馏水,搅拌加热煮沸灭菌,冷至 50℃,摇匀,倾入无菌平皿备用。无需高压灭菌。保存于黑暗处,48 小时内使用。
四、结果观察与解释
接种以下质控菌株,放置36±1℃需氧培养40-48小时。
|
质控菌株 |
菌株编号 |
生长率 |
其它特征 |
|
肠炎沙门氏菌 |
CMCC 50746 |
G≥6 |
有金属光泽,黑色菌落 |
|
鼠伤寒沙门氏菌 |
ATCC 14028 |
G≥6 |
有金属光泽,黑色或灰绿色菌落 |
|
大肠埃希氏菌 |
ATCC 25922 |
G≤1 |
- |
|
粪肠球菌 |
ATCC 29212 |
G≤1 |
- |
图A:肠炎沙门氏菌CMCC 50746 图B:鼠伤寒沙门氏菌ATCC 14028
图C:大肠埃希氏菌ATCC 25922 图D:粪肠球菌ATCC 29212
五、注意事项
1.划线时,伤寒沙门氏菌生长密集的地方出现浅绿色可能误认为非伤寒沙门氏菌。
2.不可高压灭菌,否则会降低该培养基的选择性。
相关产品:
注:本文属海博生物原创,未经允许不得转载。



